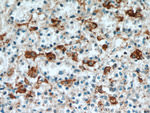
SGSM3 Antibody in Immunohistochemistry (Paraffin) (IHC (P))

Search
Proteintech
SGSM3 Polyclonal Antibody
{{$productOrderCtrl.translations['antibody.pdp.commerceCard.promotion.promotions']}}
{{$productOrderCtrl.translations['antibody.pdp.commerceCard.promotion.viewpromo']}}
{{$productOrderCtrl.translations['antibody.pdp.commerceCard.promotion.promocode']}}: {{promo.promoCode}} {{promo.promoTitle}} {{promo.promoDescription}}. {{$productOrderCtrl.translations['antibody.pdp.commerceCard.promotion.learnmore']}}
产品信息
20825-1-AP
种属反应
已发表种属
宿主/亚型
分类
类型
抗原
偶联物
形式
浓度
规格
纯化类型
保存液
内含物
保存条件
运输条件
产品详细信息
Immunogen sequence: RTQRRKSTI TALLFGEDDL EALKAKNIKQ TELVADLREA ILRVARHFQC TDPKNCSVEL TPDYSMESHQ RDHENYVACS RSHRRRAKAL LDFERHDDDE LGFRKNDIIT IVSQKDEHCW VGELNGLRGW FPAKFVEVLD ERSKEYSIAG DDSVTEGVTD LVRGTLCPAL KALFEHGLKK PSLLGGACHP WLFIEEAAGR EVERDFASVY SRLVLCKTFR LDEDGKVLTP EELLYRAVQS VNVTHDAVHA QMDVKLRSLI CVGLNEQVLH LWLEVLCSSL PTVEKWYQPW SFLRSPGWVQ IKCELRVLCC FAFSLSQDWE LPAKREAQQP LKEGVRDMLV KHHLFSWDVD G (400-749 aa encoded by BC008078)
靶标信息
May play a cooperative role in NF2-mediated growth suppression of cells. [UniProt]
仅用于科研。不用于诊断过程。未经明确授权不得转售。
生物信息学
蛋白别名: Cx43-interacting protein of 85-kDa; dJ1042K10.2; DKFZp761D051; MAP; merlin binding protein; Merlin-associated protein; Rab-GTPase-activating protein-like protein; RabGAP-5; RabGAPLP; RUN and SH3 containing 3; RUN and TBC1 domain containing 3; RUN and TBC1 domain-containing protein 3; sgsm3; Small G protein signaling modulator 3; small G protein signaling modulator 3 protein; unnamed protein product
基因别名: 1810012I01Rik; AI428557; BB175482; CIP85; MAP; R75178; RabGAP-5; RABGAP5; RABGAPLP; RUSC3; RUTBC3; SGSM3
UniProt ID: (Human) Q96HU1, (Mouse) Q8VCZ6
Entrez Gene ID: (Human) 27352, (Mouse) 105835